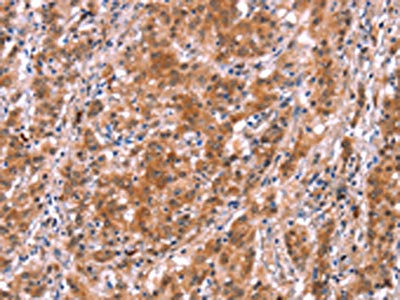

BCAR1 Antibody
-
中文名稱:BCAR1兔多克隆抗體
-
貨號:CSB-PA941444
-
規(guī)格:¥1100
-
圖片:
-
The image on the left is immunohistochemistry of paraffin-embedded Human thyroid cancer tissue using CSB-PA941444(BCAR1 Antibody) at dilution 1/15, on the right is treated with synthetic peptide. (Original magnification: ×200)
-
The image on the left is immunohistochemistry of paraffin-embedded Human gastric cancer tissue using CSB-PA941444(BCAR1 Antibody) at dilution 1/15, on the right is treated with synthetic peptide. (Original magnification: ×200)
-
-
其他:
產品詳情
-
Uniprot No.:
-
基因名:
-
別名:BCAR 1 antibody; Bcar1 antibody; BCAR1_HUMAN antibody; Breast cancer anti estrogen resistance 1 antibody; Breast cancer anti estrogen resistance 1 protein antibody; Breast cancer anti-estrogen resistance protein 1 antibody; CAS antibody; Cas scaffolding protein family member 1 antibody; CAS1 antibody; Cass1 antibody; Crk associated substrate antibody; Crk associated substrate p130Cas antibody; CRK-associated substrate antibody; CRKAS antibody; FLJ12176 antibody; FLJ45059 antibody; p130cas antibody
-
宿主:Rabbit
-
反應種屬:Human,Mouse,Rat
-
免疫原:Synthetic peptide of Human BCAR1
-
免疫原種屬:Homo sapiens (Human)
-
標記方式:Non-conjugated
-
抗體亞型:IgG
-
純化方式:Antigen affinity purification
-
濃度:It differs from different batches. Please contact us to confirm it.
-
保存緩沖液:-20°C, pH7.4 PBS, 0.05% NaN3, 40% Glycerol
-
產品提供形式:Liquid
-
應用范圍:ELISA,IHC
-
推薦稀釋比:
Application Recommended Dilution ELISA 1:1000-1:2000 IHC 1:25-1:100 -
Protocols:
-
儲存條件:Upon receipt, store at -20°C or -80°C. Avoid repeated freeze.
-
貨期:Basically, we can dispatch the products out in 1-3 working days after receiving your orders. Delivery time maybe differs from different purchasing way or location, please kindly consult your local distributors for specific delivery time.
-
用途:For Research Use Only. Not for use in diagnostic or therapeutic procedures.
相關產品
靶點詳情
-
功能:Docking protein which plays a central coordinating role for tyrosine kinase-based signaling related to cell adhesion. Implicated in induction of cell migration and cell branching. Involved in the BCAR3-mediated inhibition of TGFB signaling.
-
基因功能參考文獻:
- study showed that RBMS1 gene rs7593730 and BCAR1 gene rs7202877 were significantly associated with type 2 diabetes in the Chinese population PMID: 30188962
- These results suggest that miR-24-3p functions as a tumor suppressor and the miR-24-3p/p130Cas axis is a novel factor of cancer progression by regulating cell migration and invasion. PMID: 28337997
- The authors herein prove, for the first time, that the transcriptional repressor Blimp1 is a novel mediator of p130Cas/ErbB2-mediated invasiveness. Indeed, high Blimp1 expression levels are detected in invasive p130Cas/ErbB2 cells and correlate with metastatic status in human breast cancer patients. PMID: 28442738
- the results of our study identify BCAR1 as a prognostic biomarker with potential clinical value for risk stratification of ERG-negative prostate cancer. PMID: 29304771
- Silencing of p130Cas and inhibition of FAK activity both strongly reduced imatinib and nilotinib stimulated invasion. PMID: 27293031
- the p130Cas FAT domain uniquely confers a mechanosensing function. PMID: 28223315
- Tyrosine phosphorylation of focal adhesion kinase (FAK) and p130 Crk-associated substrate (CAS) was found to be correlated with pancreatic cancer cell invasiveness. PMID: 27400161
- Full-length and truncated p130Cas phosphorylated substrate domain molecules were expressed in breast cancer cells. Breast cancer cells expressing the full-length SD and the functional smaller SD fragment (spanning SD motifs 6-10) were injected into the mammary fat pads of mice. Both the complete and truncated SD significantly increased the occurrence of metastases to multiple organs. PMID: 26867768
- Elevated levels of p130Cas is associated with trastuzumab resistance in breast cancer. PMID: 26716506
- blockade of GD3-mediated growth signaling pathways by siRNAs might be a novel and promising therapeutic strategy against malignant melanomas, provided signaling molecules such as p130Cas and paxillin are significantly expressed in individual cases. PMID: 27068854
- expression quantitative trait loci studies implicate BCAR1 as the causal gene of coronary artery disease Carotid intima-media thickness PMID: 26276885
- p130(Cas) exon 1 variants display altered functional properties; shorter 1B isoform exhibited diminished FAK binding activity + reduced cell migration + invasion; longest variant 1B1 exhibited the most efficient FAK binding + greatly enhanced migration PMID: 25805500
- these data identify a new p130Cas/Cyclooxygenase-2 axis as a crucial element in the control of breast tumor plasticity. PMID: 23098208
- Data introduce hitherto unappreciated paradigms whereby reactive oxygen species can reciprocally regulate the cellular localization of pro- and anti-migratory signaling molecules, p130cas and PTEN, respectively. PMID: 24494199
- BCAR1 has a pivotal role in the regulation of tissue homeostasis in pathological conditions such as cancer. (Review) PMID: 25727852
- Cas promotes cell migration by linking actomyosin contractions to the adhesion complexes through interaction with Src and the actin cytoskeleton. PMID: 24928898
- Collectively, these studies demonstrate that p130Cas acts as a bridging molecule between the Kaposi's sarcoma-associated herpesvirus-induced entry signal complex and the downstream trafficking signalosome in endothelial cells. PMID: 25253349
- Our results show that endogenous Cul5 suppresses epithelial cell transformation by several pathways, including inhibition of Src-Cas-induced ruffling through SOCS6 PMID: 24284072
- Increased BCAR1 expression is associated with non-small cell lung cancer. PMID: 23904007
- P130Cas overexpression synergizes with ErbB2 in mammary cell transformation and promotes ErbB2-dependent invasion. PMID: 23839042
- Our results suggest that elevated expression and tyrosine phosphorylation of p130Cas contributes to the resistance to TGF-beta-induced growth inhibition. PMID: 23872147
- Data indicate that Abi1 is activated by the c-Abl-Crk-associated substrate (CAS) pathway, and Abi1 reciprocally controls the activation of its upstream regulator c-Abl. PMID: 23740246
- p130Cas acts as survival factor by limiting PMA-mediated cell cluster disruption and resulting cell death in HL-60 cells. PMID: 23287717
- Disruption of p130Cas attenuates both invasion and migration of the metastatic variant PMID: 23345605
- This study identified rs4888378 in the BCAR1-CFDP1-TMEM170A locus as a novel genetic determinant of carotid intima-media thickness and coronary artery disease risk. PMID: 23152477
- BCAR1 rs7202877 may mediate its diabetogenic impact through impaired beta-cell function. PMID: 23457408
- These results suggest that alteration of morphogenetic pathways due to p130Cas over-expression might prime mammary epithelium to tumorigenesis PMID: 23239970
- The aim of this study is to evaluate the role of p130cas, E-cadherin, and beta-catenin expression in patients with non-small cell lung cancer. PMID: 23042269
- Study shows that BCAR4 expression identifies a subgroup of ER-positive breast cancer patients without overexpression of ERBB2 who have a poor outcome and might benefit from combined ERBB2-targeted and antioestrogen therapy. PMID: 22892392
- BCAR1 is an independent predictor of recurrence following radical prostatectomy for "low risk" prostate cancer. PMID: 22241677
- Overexpression of BCAR1 is a predictor of poor prognosis in non-small-cell lung cancer and plays important carcinogenic roles in carcinogenesis. PMID: 22558353
- Data show that phosphorylation of Src family kinases and the adaptor protein p130CAS, resulting in actin recruitment and CD36 clustering by 50-60% of adherent beads. PMID: 22106368
- These findings reveal an important role of CAS Y12 phosphorylation in the regulation of focal adhesion assembly, cell migration, and invasiveness of Src-transformed cells. PMID: 21937722
- a novel function for PTK6 at the plasma membrane PMID: 22084245
- p130Cas signaling induces the expression of EGR1 and NAB2 PMID: 22431919
- CrkI and p130(Cas) complex regulates the migration and invasion of prostate cancer cells. PMID: 22144090
- Immunohistochemical analysis of microarrayed human oral squamous cell carcinoma revealed a significant correlation between uPAR and p130cas expression. PMID: 21630091
- The structure of the NSP3-p130Cas complex reveals that this closed conformation is instrumental for interaction of NSP proteins with a focal adhesion-targeting domain present in Cas proteins. PMID: 22081014
- Increased p130cas expression is associated with poor clinical outcome in human ovarian carcinoma, and p130cas gene silencing decreases tumor growth through stimulation of apoptotic and autophagic cell death. PMID: 21957230
- Cas proteins do not affect E-cadherin transcription, but rather, BCAR1 and NEDD9 signal through SRC to promote E-cadherin removal from the cell membrane and lysosomal degradation. PMID: 21765937
- Analyses indicate that p130Cas expression in ErbB2 positive human breast cancers significantly correlates with higher risk to develop distant metastasis, thus underlying the value of the p130Cas/ErbB2 synergism in regulating breast cancer invasion. PMID: 20961652
- p130Cas, Src and talin function in both oral carcinoma invasion and resistance to cisplatin. PMID: 21291860
- BCAR-1 is a physiological substrate of Syk. PMID: 21047529
- CAS plays a role in regulating the extension of cell protrusions and promotes the migration of cancer cells. PMID: 20688056
- The crucial interactions required for anti-estrogen resistance occur within the substrate domain of BCAR1 PMID: 19412734
- Tyrosine phosphorylation of p130CAS regulates localization and downstream signaling with profound affects on cell movement. PMID: 11779709
- Binding of the adapter protein p130Cas to the C-terminal of Pyk2 in cultured human umbilical vein endothelial cells is phosphorylation-independent and is not affected by acute exposure to thrombin. PMID: 11820787
- The association of Cas with Wiskott-Aldrich syndrome protein is associated with cell migration in stromal cell-derived factor-1alpha-stimulated Jurkat cells PMID: 12135674
- phosphorylation of p130(Cas) can prevent cells from anoikis and contribute to tumor cell anchorage independence and metastasis PMID: 12397603
- R-Ras promotes focal adhesion formation by signaling to FAK and p130(Cas) through a novel mechanism that differs from but synergizes with the alpha2beta1 integrin. PMID: 12529399
顯示更多
收起更多
-
亞細胞定位:Cell junction, focal adhesion. Cytoplasm. Cell projection, axon.
-
蛋白家族:CAS family
-
組織特異性:Widely expressed with an abundant expression in the testis. Low level of expression seen in the liver, thymus, and peripheral blood leukocytes. The protein has been detected in a B-cell line.
-
數據庫鏈接:
Most popular with customers
-
-
YWHAB Recombinant Monoclonal Antibody
Applications: ELISA, WB, IHC, IF, FC
Species Reactivity: Human, Mouse, Rat
-
Phospho-YAP1 (S127) Recombinant Monoclonal Antibody
Applications: ELISA, WB, IHC
Species Reactivity: Human
-
-
-
-
-